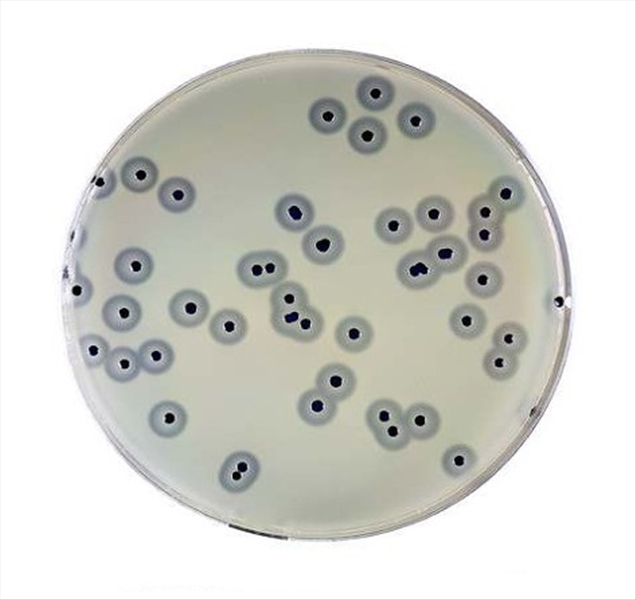

BAIRD PARKER AGAR BASE 6X100 ML
- Disponibilité limitée
- Code: L032595
Utilisateur NON autorisé à procéder au devis.
Zone réservée Ajouter aux favorisDescription
BAIRD PARKER AGAR BASE (ISO 6888). Usare con:Egg Yolk Tellurite Emulsion 20% 423700
Oppure con:
RPF Supplement II L004599
5111162









